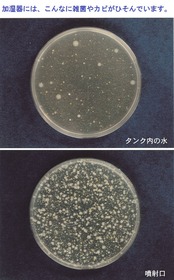

・翌月にまとめてお支払い可能
・手数料無料(口座振替の場合)
・アプリでご利用金額を確認できて安心

¥1,716 税込
なら 手数料無料の 翌月払いでOK
この商品は送料無料です。
コジット 加湿器タンクの除菌剤 ラベンダー
サイズ:幅3.9×奥行3.9×高さ12cm
重量:0.13kg
材質:成分/ラベンダーエキス・アザディラクチン(ニームオイル)・大豆エキス・穀物エキス・界面活性剤・水
原産国:日本
※パッケージデザインは予告なく変更する場合があります
加湿器タンクの除菌剤 ラベンダー 100mL コジット
送料・配送方法について
お支払い方法について